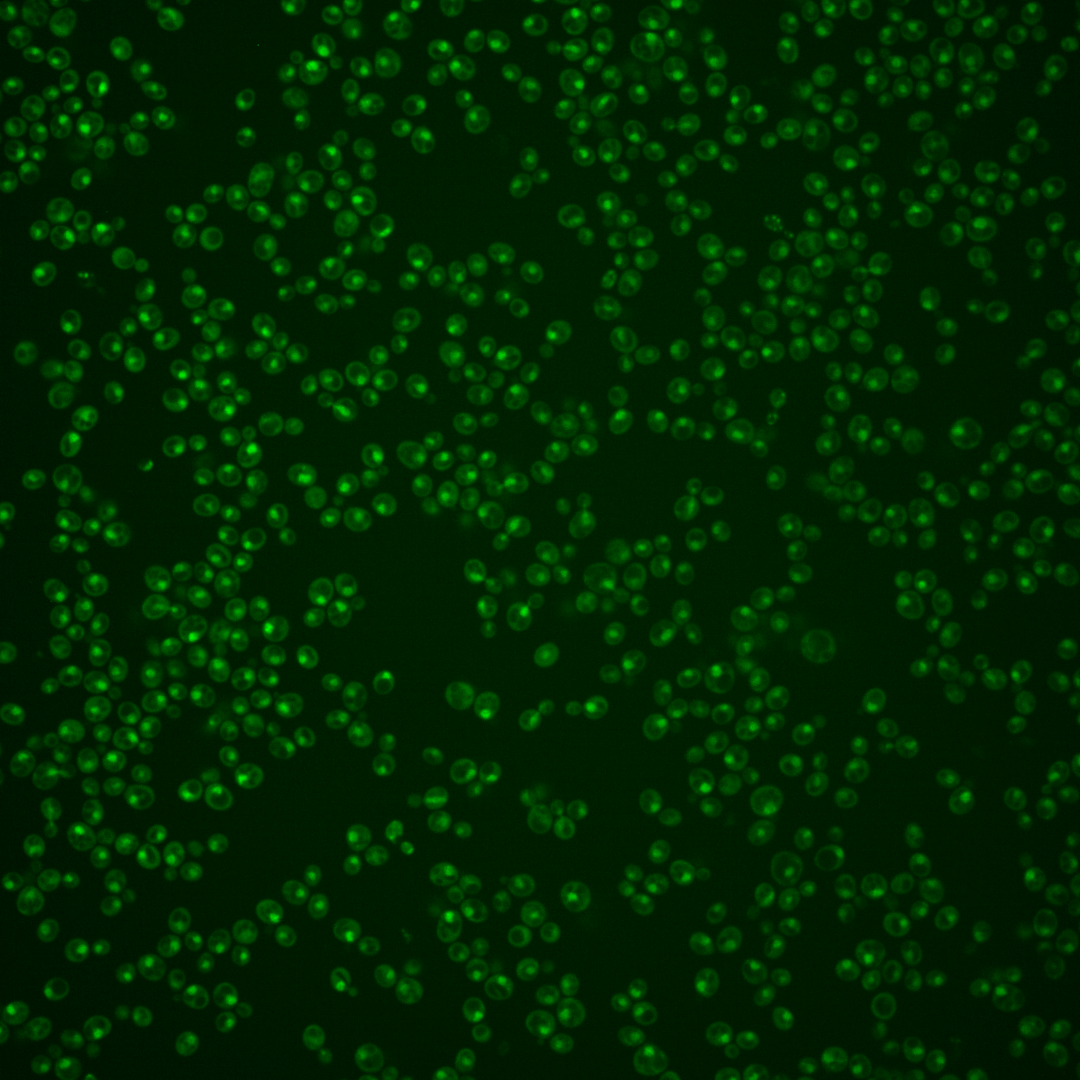
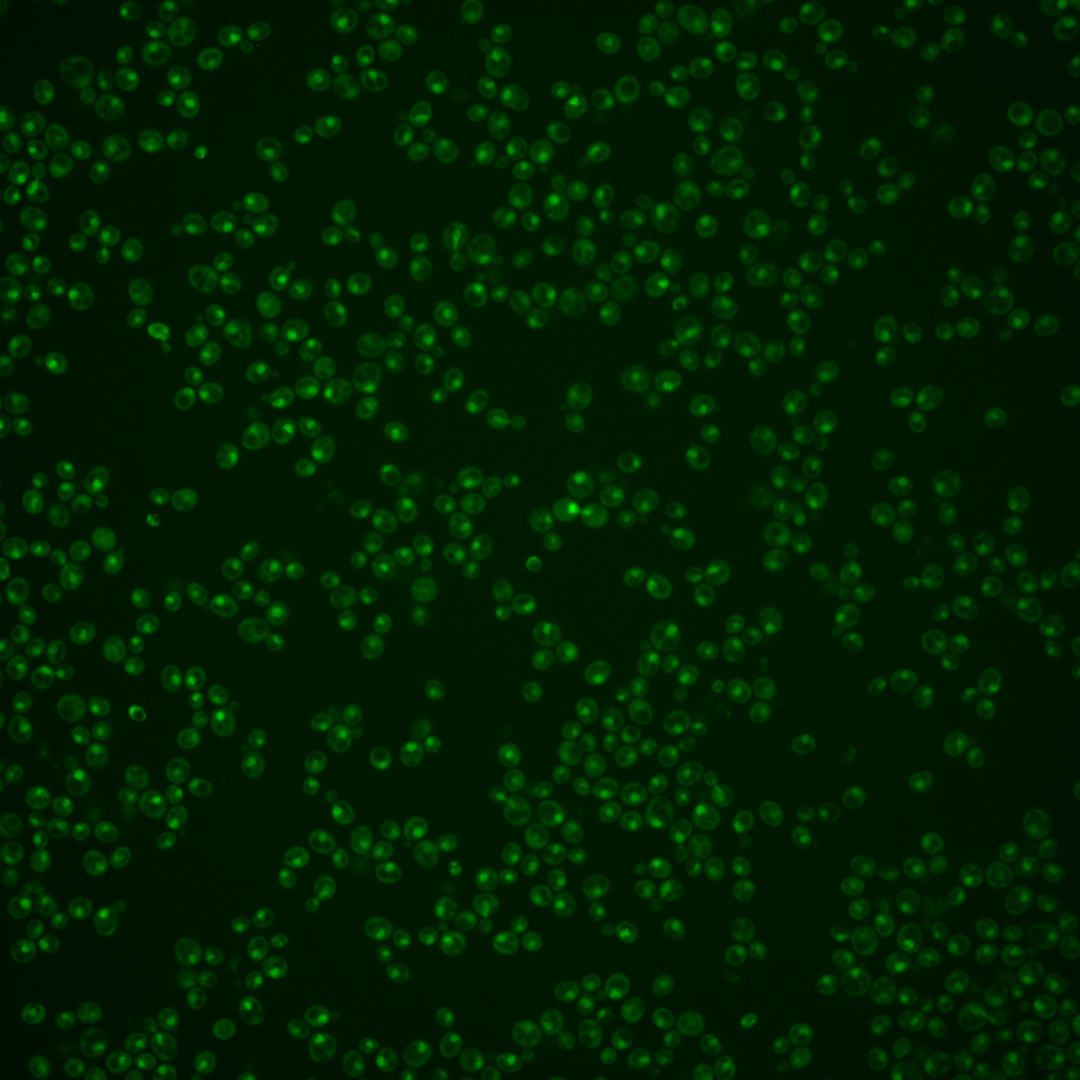

| Standard name | |
|---|---|
| Human Ortholog | |
| Description | Protein of unknown function; component of the Swr1p complex that incorporates Htz1p into chromatin |
Micrographs




















































































Sub-cellular Localization
Yeast GFP Assignment
Protein Abundance
Localization Change
External localization resources
| ensLOC | DeepLoc | |||||||||||||||||||||||
|---|---|---|---|---|---|---|---|---|---|---|---|---|---|---|---|---|---|---|---|---|---|---|---|---|
| Localization | WT1 | WT2 | WT3 | RAP60 | RAP140 | RAP220 | RAP300 | RAP380 | RAP460 | RAP540 | RAP620 | RAP700 | HU80 | HU120 | HU160 | rpd3Δ_1 | rpd3Δ_2 | rpd3Δ_3 | WT1 | WT2 | WT3 | AF100 | AF140 | AF180 |
| Cortical Patches | 0 | 0 | 0 | 0 | 0 | 0 | – | 0 | 0 | 0 | 0 | 0 | 0 | 0 | 0 | 1 | 0 | 0 | 0 | 0 | 0 | 0 | 1 | 0 |
| Bud | 0 | 0 | 0 | 1 | 0 | 0 | – | 6 | 2 | 2 | 2 | 3 | 0 | 0 | 1 | 0 | 0 | 0 | 5 | 1 | 0 | 1 | 5 | 10 |
| Bud Neck | 0 | 0 | 0 | 0 | 0 | 0 | – | 1 | 0 | 0 | 0 | 0 | 0 | 0 | 0 | 0 | 0 | 0 | 0 | 0 | 0 | 0 | 1 | 4 |
| Bud Site | 2 | 0 | 0 | 1 | 2 | 8 | – | 9 | 8 | 20 | 6 | 10 | 0 | 0 | 0 | 0 | 0 | 0 | – | – | – | – | – | – |
| Cell Periphery | 0 | 0 | 0 | 0 | 0 | 0 | – | 0 | 0 | 0 | 0 | 0 | 0 | 0 | 0 | 0 | 0 | 0 | 0 | 0 | 0 | 0 | 0 | 0 |
| Cytoplasm | 6 | 3 | 9 | 7 | 18 | 16 | – | 22 | 11 | 17 | 12 | 17 | 27 | 59 | 73 | 11 | 20 | 18 | 0 | 2 | 3 | 0 | 5 | 11 |
| Endoplasmic Reticulum | 1 | 0 | 0 | 0 | 0 | 0 | – | 0 | 0 | 0 | 0 | 0 | 3 | 1 | 0 | 3 | 5 | 6 | 0 | 0 | 0 | 0 | 2 | 0 |
| Endosome | 0 | 0 | 0 | 0 | 2 | 0 | – | 0 | 0 | 0 | 0 | 1 | 1 | 1 | 8 | 6 | 3 | 6 | 5 | 0 | 1 | 2 | 5 | 7 |
| Golgi | 0 | 0 | 0 | 0 | 0 | 0 | – | 0 | 0 | 0 | 0 | 0 | 0 | 1 | 1 | 0 | 1 | 0 | 0 | 0 | 0 | 0 | 2 | 1 |
| Mitochondria | 143 | 6 | 52 | 70 | 49 | 125 | – | 170 | 124 | 182 | 106 | 188 | 19 | 29 | 9 | 7 | 5 | 6 | 6 | 2 | 1 | 1 | 5 | 7 |
| Nucleus | 449 | 106 | 62 | 85 | 145 | 125 | – | 215 | 101 | 164 | 99 | 132 | 263 | 341 | 358 | 37 | 38 | 59 | 426 | 100 | 60 | 71 | 212 | 253 |
| Nuclear Periphery | 0 | 1 | 0 | 1 | 0 | 1 | – | 2 | 1 | 2 | 0 | 0 | 1 | 1 | 3 | 0 | 1 | 0 | 0 | 0 | 0 | 0 | 0 | 1 |
| Nucleolus | 12 | 8 | 1 | 7 | 10 | 14 | – | 15 | 16 | 15 | 11 | 11 | 18 | 22 | 29 | 3 | 2 | 2 | 30 | 11 | 4 | 15 | 52 | 46 |
| Peroxisomes | 0 | 0 | 0 | 0 | 0 | 0 | – | 0 | 0 | 0 | 0 | 0 | 0 | 1 | 0 | 0 | 0 | 0 | 0 | 0 | 0 | 0 | 0 | 0 |
| SpindlePole | 4 | 1 | 0 | 2 | 3 | 0 | – | 2 | 2 | 4 | 1 | 1 | 6 | 3 | 14 | 1 | 1 | 0 | 7 | 0 | 0 | 5 | 16 | 22 |
| Vac/Vac Membrane | 3 | 0 | 1 | 1 | 0 | 5 | – | 4 | 2 | 5 | 1 | 4 | 3 | 3 | 3 | 25 | 15 | 27 | 21 | 4 | 5 | 6 | 32 | 33 |
| Unique Cell Count | 484 | 116 | 84 | 110 | 184 | 197 | 314 | 173 | 267 | 154 | 233 | 306 | 421 | 454 | 82 | 82 | 104 | 508 | 125 | 81 | 109 | 347 | 409 | |
| Labelled Cell Count | 620 | 125 | 125 | 175 | 229 | 294 | 446 | 267 | 411 | 238 | 367 | 341 | 462 | 499 | 94 | 91 | 124 | 508 | 125 | 81 | 109 | 347 | 409 | |
Yeast GFP Assignment
Protein Abundance
| Screen | WT1 | WT2 | WT3 | RAP60 | RAP140 | RAP220 | RAP300 | RAP380 | RAP460 | RAP540 | RAP620 | RAP700 | HU80 | HU120 | HU160 | rpd3Δ_1 | rpd3Δ_2 | rpd3Δ_3 | AF100 | AF140 | AF180 |
|---|---|---|---|---|---|---|---|---|---|---|---|---|---|---|---|---|---|---|---|---|---|
| Mean Cell GFP Intensity (1e-4) | 4.6 | 5.5 | 3.9 | 4.3 | 4.7 | 3.7 | – | 4.0 | 3.5 | 3.6 | 3.6 | 3.5 | 5.5 | 5.5 | 5.8 | 8.0 | 8.3 | 8.5 | 5.0 | 5.5 | 5.4 |
| Std Deviation (1e-4) | 0.6 | 0.8 | 1.9 | 2.4 | 1.4 | 1.3 | – | 1.6 | 1.7 | 1.2 | 1.7 | 1.5 | 1.9 | 1.5 | 2.0 | 1.9 | 2.3 | 1.7 | 1.4 | 1.6 | 1.8 |
| Intensity Change (Log2) | – | – | – | 0.14 | 0.26 | -0.07 | – | 0.04 | -0.18 | -0.1 | -0.13 | -0.17 | 0.49 | 0.5 | 0.56 | 1.03 | 1.09 | 1.12 | 0.34 | 0.48 | 0.47 |
Localization Change
| Localization | RAP60 | RAP140 | RAP220 | RAP300 | RAP380 | RAP460 | RAP540 | RAP620 | RAP700 | HU80 | HU120 | HU160 | rpd3Δ_1 | rpd3Δ_2 | rpd3Δ_3 |
|---|---|---|---|---|---|---|---|---|---|---|---|---|---|---|---|
| Cortical Patches | 0 | 0 | 0 | – | 0 | 0 | 0 | 0 | 0 | 0 | 0 | 0 | 0 | 0 | 0 |
| Bud | 0 | 0 | 0 | – | 0 | 0 | 0 | 0 | 0 | 0 | 0 | 0 | 0 | 0 | 0 |
| Bud Neck | 0 | 0 | 0 | – | 0 | 0 | 0 | 0 | 0 | 0 | 0 | 0 | 0 | 0 | 0 |
| Bud Site | 0 | 0 | 0 | – | 0 | 0 | 0 | 0 | 0 | 0 | 0 | 0 | 0 | 0 | 0 |
| Cell Periphery | 0 | 0 | 0 | – | 0 | 0 | 0 | 0 | 0 | 0 | 0 | 0 | 0 | 0 | 0 |
| Cytoplasm | -1.1 | -0.2 | -0.7 | – | -1.1 | -1.2 | -1.3 | -0.8 | -1.0 | -0.5 | 0.8 | 1.3 | 0.5 | 2.3 | 1.3 |
| Endoplasmic Reticulum | 0 | 0 | 0 | – | 0 | 0 | 0 | 0 | 0 | 0 | 0 | 0 | 0 | 0 | 0 |
| Endosome | 0 | 0 | 0 | – | 0 | 0 | 0 | 0 | 0 | 0 | 0 | 0 | 0 | 0 | 0 |
| Golgi | 0 | 0 | 0 | – | 0 | 0 | 0 | 0 | 0 | 0 | 0 | 0 | 0 | 0 | 0 |
| Mitochondria | 0 | 0 | 0 | – | 0 | 0 | 0 | 0 | 0 | -11.7 | -12.5 | -15.9 | -7.2 | -7.6 | -8.3 |
| Nucleus | 0.6 | 0.9 | -1.7 | – | -0.9 | -2.4 | -2.1 | -1.5 | -2.8 | 2.6 | 1.5 | 1.0 | -3.8 | -3.6 | -2.4 |
| Nuclear Periphery | 0 | 0 | 0 | – | 0 | 0 | 0 | 0 | 0 | 0 | 0 | 0 | 0 | 0 | 0 |
| Nucleolus | 0 | 0 | 0 | – | 0 | 0 | 0 | 0 | 0 | 0 | 0 | 0 | 0 | 0 | 0 |
| Peroxisomes | 0 | 0 | 0 | – | 0 | 0 | 0 | 0 | 0 | 0 | 0 | 0 | 0 | 0 | 0 |
| SpindlePole | 0 | 0 | 0 | – | 0 | 0 | 0 | 0 | 0 | 0 | 0 | 0 | 0 | 0 | 0 |
| Vacuole | 0 | 0 | 0 | – | 0 | 0 | 0 | 0 | 0 | 0 | 0 | 0 | 5.2 | 3.7 | 4.7 |
External localization resources
Images






























Protein Concentration and Protein Localization Data
| R1 | R2 | R3 | ||||||||||||||||
|---|---|---|---|---|---|---|---|---|---|---|---|---|---|---|---|---|---|---|
| G1 Pre-START | G1 Post-START | S/G2 | Metaphase | Anaphase | Telophase | G1 Pre-START | G1 Post-START | S/G2 | Metaphase | Anaphase | Telophase | G1 Pre-START | G1 Post-START | S/G2 | Metaphase | Anaphase | Telophase | |
| Concentration | 1.2331 | 1.3817 | 1.4456 | 0.6803 | 1.0906 | 1.0894 | 1.0963 | 1.0275 | 1.2378 | 0.9945 | 1.2036 | 0.938 | 1.9789 | 2.3091 | 2.2694 | 2.0043 | 2.5235 | 2.1621 |
| Actin | 0.015 | 0 | 0.002 | 0.0011 | 0.0046 | 0.0004 | 0.0221 | 0 | 0.0023 | 0.0038 | 0.0045 | 0.0002 | 0.0303 | 0 | 0.0086 | 0.0021 | 0.0081 | 0.0074 |
| Bud | 0.0006 | 0.0001 | 0.0002 | 0.0001 | 0.0044 | 0.0001 | 0.0008 | 0 | 0.0002 | 0.0002 | 0.0006 | 0.0001 | 0.0003 | 0 | 0.0001 | 0.0001 | 0.0003 | 0.0001 |
| Bud Neck | 0.0027 | 0.0002 | 0.0006 | 0.0005 | 0.0049 | 0.0014 | 0.0067 | 0.0001 | 0.0007 | 0.0004 | 0.0024 | 0.0011 | 0.0026 | 0.0001 | 0.0004 | 0.0002 | 0.0022 | 0.0027 |
| Bud Periphery | 0.0019 | 0.0001 | 0.0005 | 0.0003 | 0.0103 | 0.0003 | 0.0017 | 0 | 0.0003 | 0.0006 | 0.0014 | 0.0003 | 0.0005 | 0 | 0.0003 | 0.0001 | 0.0008 | 0.0001 |
| Bud Site | 0.0055 | 0.0003 | 0.0038 | 0.0004 | 0.0227 | 0.0002 | 0.0098 | 0.0001 | 0.0016 | 0.0003 | 0.0019 | 0.0003 | 0.0012 | 0.0001 | 0.0003 | 0.0002 | 0.001 | 0.0002 |
| Cell Periphery | 0.0005 | 0 | 0.0002 | 0.0001 | 0.0012 | 0.0001 | 0.0012 | 0 | 0.0001 | 0.0004 | 0.0001 | 0 | 0.0001 | 0 | 0 | 0 | 0.0001 | 0 |
| Cytoplasm | 0.0097 | 0.0002 | 0.0015 | 0.0001 | 0.0016 | 0.0001 | 0.0025 | 0.0008 | 0.0012 | 0.0015 | 0.0012 | 0.0004 | 0.0067 | 0.0003 | 0.0002 | 0.0027 | 0.0024 | 0.0002 |
| Cytoplasmic Foci | 0.0216 | 0.0003 | 0.004 | 0.0102 | 0.019 | 0.0003 | 0.0134 | 0 | 0.0046 | 0.0016 | 0.0236 | 0.0006 | 0.0135 | 0 | 0.0023 | 0.001 | 0.0047 | 0.0005 |
| Eisosomes | 0.0001 | 0 | 0.0001 | 0 | 0.0002 | 0 | 0.0004 | 0 | 0 | 0.0003 | 0.0001 | 0 | 0.0003 | 0 | 0.0001 | 0 | 0.0001 | 0.0001 |
| Endoplasmic Reticulum | 0.0011 | 0 | 0.0009 | 0.0001 | 0.001 | 0.0001 | 0.0042 | 0 | 0.0006 | 0.0013 | 0.001 | 0.0004 | 0.0019 | 0 | 0.0003 | 0.0015 | 0.0017 | 0.0004 |
| Endosome | 0.0215 | 0.0002 | 0.0103 | 0.0107 | 0.0274 | 0.001 | 0.0211 | 0 | 0.0057 | 0.0093 | 0.0335 | 0.0058 | 0.0153 | 0 | 0.0028 | 0.0104 | 0.0105 | 0.0024 |
| Golgi | 0.0075 | 0.0002 | 0.0041 | 0.0079 | 0.016 | 0.0007 | 0.0074 | 0 | 0.0028 | 0.011 | 0.016 | 0.0012 | 0.0051 | 0 | 0.0016 | 0.0006 | 0.002 | 0.001 |
| Lipid Particles | 0.026 | 0.0066 | 0.0089 | 0.0335 | 0.0456 | 0.0027 | 0.0154 | 0 | 0.0185 | 0.0118 | 0.0128 | 0.0031 | 0.0175 | 0 | 0.0065 | 0.0007 | 0.0183 | 0.0016 |
| Mitochondria | 0.0074 | 0.0012 | 0.0063 | 0.0318 | 0.0505 | 0.0118 | 0.013 | 0.0001 | 0.0032 | 0.0408 | 0.0481 | 0.002 | 0.0039 | 0.0001 | 0.0012 | 0.0019 | 0.0102 | 0.0003 |
| None | 0.001 | 0.0001 | 0.0008 | 0.0001 | 0.0006 | 0 | 0.0013 | 0.0022 | 0.0002 | 0.0216 | 0.0008 | 0.0001 | 0.0087 | 0 | 0.0003 | 0.0012 | 0.0023 | 0.0006 |
| Nuclear Periphery | 0.0074 | 0.002 | 0.004 | 0.0003 | 0.0036 | 0.0092 | 0.0161 | 0.0015 | 0.0016 | 0.0017 | 0.0146 | 0.0013 | 0.0174 | 0.002 | 0.0008 | 0.0284 | 0.0222 | 0.0038 |
| Nucleolus | 0.0329 | 0.0196 | 0.0141 | 0.0094 | 0.0978 | 0.0528 | 0.0302 | 0.0148 | 0.0169 | 0.0231 | 0.0947 | 0.0663 | 0.0179 | 0.0112 | 0.016 | 0.015 | 0.0623 | 0.0577 |
| Nucleus | 0.8022 | 0.9611 | 0.9271 | 0.8722 | 0.6467 | 0.9144 | 0.7949 | 0.9751 | 0.9268 | 0.8623 | 0.6887 | 0.9127 | 0.815 | 0.9838 | 0.9493 | 0.9224 | 0.8215 | 0.9136 |
| Peroxisomes | 0.0138 | 0.0006 | 0.002 | 0.0167 | 0.0094 | 0.0003 | 0.0144 | 0 | 0.0071 | 0.0011 | 0.0116 | 0.0007 | 0.023 | 0 | 0.007 | 0.0002 | 0.0179 | 0.0019 |
| Punctate Nuclear | 0.0084 | 0.0068 | 0.0059 | 0.0009 | 0.0071 | 0.0032 | 0.0157 | 0.0051 | 0.0037 | 0.001 | 0.0392 | 0.0024 | 0.0167 | 0.0021 | 0.0016 | 0.0095 | 0.0097 | 0.0048 |
| Vacuole | 0.0113 | 0.0001 | 0.002 | 0.0021 | 0.0198 | 0.0005 | 0.0051 | 0 | 0.0014 | 0.004 | 0.0016 | 0.0007 | 0.001 | 0.0001 | 0.0003 | 0.0007 | 0.0009 | 0.0002 |
| Vacuole Periphery | 0.0018 | 0.0001 | 0.0008 | 0.0015 | 0.0057 | 0.0004 | 0.0025 | 0 | 0.0003 | 0.0019 | 0.0015 | 0.0005 | 0.001 | 0 | 0.0002 | 0.0009 | 0.001 | 0.0002 |
Sequencing Data
| R1 | R2 | |||||||||
|---|---|---|---|---|---|---|---|---|---|---|
| G1 Post-START | S/G2 | Metaphase | Anaphase | Telophase | G1 Post-START | S/G2 | Metaphase | Anaphase | Telophase | |
| Gene Expression | 23.5061 | 9.8885 | 3.6688 | 10.5591 | 14.342 | 11.0556 | 12.4978 | 9.2787 | 6.6046 | 17.0548 |
| Translational Efficiency | 1.0232 | 1.2039 | 2.4544 | 0.6435 | 0.7289 | 2.4439 | 0.6843 | 0.5047 | 1.1301 | 0.9507 |
Hit Data
| Dataset | Hit |
|---|---|
| Protein Concentration | ✘ |
| Protein Localization | ✘ |
| Gene Expression | ✘ |
| Translational Efficiency | ✘ |
Endocytosis
| Temp | Actin Patch (Sac6-tdTomato) | Cortical Patch (Sla1-GFP) | Late Endosome (Snf7-GFP) | Vacuole (Vph1-GFP) |
|---|---|---|---|---|
| 37℃ | ||||
| RT |
Cell Cycle Omics
CYCLoPs (Swc7-GFP)
| Gene / Allele | Actin Patch (Sac6-tdTomato) | Cortical Patch (Sla1-GFP) | Late Endosome (Snf7-GFP) | Vacuole (Sac6-tdTomato) |
|---|
| Gene | Images |
|---|
| Gene | Images |
|---|
Images are not yet available
Images are not yet available